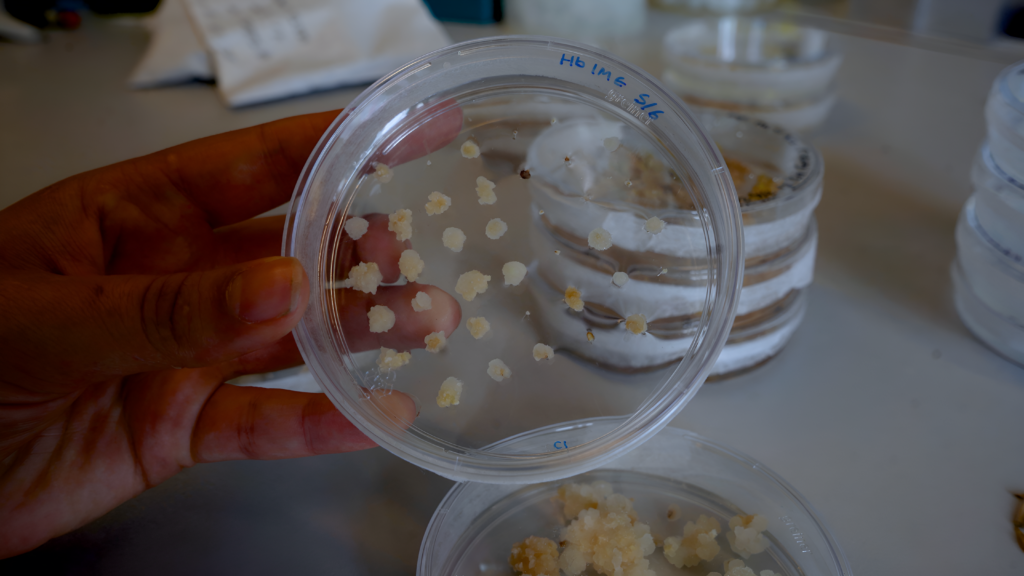
Planteceller i petriskål i laboratorie efter CRISPR genredigering og mutation

En af de mest præcise måder man kan ændre gener på i dag, er ved at bruge CRISPR, fordi teknologien gør det muligt hurtigt og målrettet at redigere DNA.
CRISPR-Cas er oprindeligt en del af bakteriers naturlige immunforsvar mod virus, hvor det kan genkende og klippe fremmed DNA. Dette system udnytter forskere ved at designe et særligt sgRNA, som guider CRISPR-Cas til et bestemt sted i planters arvemasse, hvor den klipper i DNA’et.
Når DNA’et klippes, vil cellen forsøge at reparere skaden og i denne reparationsproces kan der opstå små fejl – disse fejl kaldes mutationer. Mutationerne kan ændre plantens genetik på måder, som viser sig, når den efterfølgende vokser i drivhuset.
CRISPR er en længere forkortelse for ’Clustred Regularly Interspaced Short Palindromic Repeats’ på engelsk, som henviser til bestemte gentagende DNA-sekvenser i bakterier.
Cas står for ”CRISPR-associated proteins”, altså de proteiner der fungerer som ’saksen’ og kan klippe i DNA.
Tilsammen betyder det ”CRISPR-Cas” = et forsvarssystem i bakterier, som forskere udnytter til genredigering. Forskere bruger normalt Cas9 til opgaven.
Middel til ønskede mutationer
Der er flere forskningsmæssige motivationer bag anvendelsen af genmodificeringsværktøjer som CRISPR/Cas-9 i planter, da teknologien kan bruges til at ændre egenskaber fra ældre og mere bæredygtige, men mindre dyrkningsvenlige plantearter, udvikle nye plantesorter med ønskede egenskaber eller gøre plante mere resistente overfor sygdomme. Den kan også bruges til at undersøge, hvordan bestemte gener påvirker plantens vækst og funktion.
Menneskeskabte mutationer bliver her midlet til at nå målet.

En mutation betyder ganske enkelt en ændring i en organismes arvemasse – typisk på gen-niveau. Et gen er en specifik del af DNA-molekylestrenge, som koder for proteindannelse og dermed bestemte egenskaber Mennesker har ca. 20.000-25.000 gener, men nogle planter som hvede har omkring 100.000 gener, hvilket gør deres arvemasse mere kompleks.
Gener kan ændre sig under cellens normale DNA-replikation, eller det kan blive beskadiget af ydre påvirkninger, såsom radioaktiv stråling eller UV-stråler fra solen. Eller ved at bruge CRISPR for at lave præcisions mutationer.
Når der sker en skade på DNA’et vil cellen automatisk forsøge at reparere den. Opstår der eksempelvis et brud på DNA-strengen, vil cellen forsøge at samle enderne igen.
Denne proces er dog ikke altid helt præcis og der kan derfor indsættes eller fjernes enkelte baser (nukleotider). Det betyder i praksis at DNA-sekvensen ændres, og der opstår en mutation. Mutationer kan være skadelige, neutrale eller gavnlige afhængigt af, hvordan de påvirker organismens funktion.
Hos planter kan det for eksempel være mutationer, der gør dem mere modtagelige overfor sygdomme eller skadedyr – eller påvirker deres klorofylproduktion. Men det kan også være noget, der gør, at de vokser større kerner (ideelt til menneskeligt konsum).
Genetisk saks i laboratoriet
Mennesker kan anvende CRISPR-Cas som en slags ”molekylær saks”, der kan klippe lige præcis i de steder i arvemassen /DNA’et, man gerne vil ændre for at få nogle bedre dyrknings- og forbrugsegenskaber.
For at CRISPR-Cas kan klippe i DNA’et, kræver det også en sgRNA – en guide, som er en lille stump arvemasse identisk med den del af plantens arvemasse, der skal ændres. Når Cas9 er guidet frem til sit mål, vil den lave tilfældige ændringer i arvemassen der, og kun der.
Før ’operationen’ designes sgRNA-sekvensen ved hjælp af bioinformatiske databaser og analyseværktøjer, hvor forskeren identificerer en sekvens på omkring 20 nukleotider (eller baser) identiske med DNA i genet, man vil ændre. Efter bestilling får man en tube med DNA’en i, som opløses i vand i laboratoriet.


Først designes sgRNA-sekvensen altså på computeren. Derefter bestilles og indsættes den sammen med de øvrige CRISPR-Cas-komponenter i en vektor, et leveringssystem, der kan føre CRISPR-systemet ind i værtscellen. Inde i cellen vil sgRNA guide Cas til det ønskede sted i DNA’et, hvor Cas 9 klipper.
Hvordan introducerer man så CRISPR i plantens celler? En af metoderne er biolistisk transformation, hvor DNA-belagte guldpartiker skydes ind i plantecellerne ved hjælp af tryk. Der findes dog også andre metoder – eksempelvis brug af bakterier, som overfører genetisk materiale til planten, eller brug af protoplasttransformation, hvor planteceller uden cellevæg kan optage genetisk materiale direkte.
Plantematerialet skal først gøres klar til genredigering. I dette tilfælde anvendes udifferentieret kallus, som består af planteceller, der endnu ikke har specialiseret sig til at udføre en bestemt funktion i plantens væv.
En metode, der ofte anvendes til græsser, herunder byg, er den førstnævnte biolistiske transformation ved brug af guldpartikler. Her belægges små guldpartikler med CRISPR hvorefter de skydes ind i cellerne under højt tryk.
På den måde kan CRISPR-Cas-komponenter introduceres i cellerne og begynde at klippe.
Selektionsmarkør spotter succes
Efter ‘operationen’ går det højst en time, før forskeren kan spotte, om mutationen er lykkedes. Forinden er der nemlig blevet tilført et kontrolmarkør i form af GFP (Green floursent protein) til plantens stamcelle.
De små planteceller bliver selvlysende, hvis de har optaget det ønskede genetiske materiale. Det skyldes et reporter-gen, der koder for et fluorescerende protein. Det er kun synligt under særligt lys, typisk blåt lys eller UV-lys. For eksempel exciteres det ofte ved blåt lys, hvorefter det udsender grønt lys med en bølgelængde omkring 508–509 nm.
Fluorescensen fungerer som en visuel markør. De celler, der lyser op, udvælges og overføres til et nyt vækstmedie, hvor de kan udvikle sig videre. Vækstmediet indeholder en nøje afstemt kombination af plantehormoner, som stimulerer cellerne til først at danne skud og siden rødder, så de gradvist kan udvikle sig til en hel plante.


Nu vil der gå 2-4 måneder, før planten har udviklet sig nok, til at man kan begynde at undersøge den nærmere.
Allerede tidligt kan man teste om den genetiske ændring faktisk er sket ved at analysere DNA’et. Men det tager længere tid at se om ændringen også påvirker plantens egenskaber – altså fænotypen. Først når planten vokser og udvikler blade, rødder og aks, kan man reelt vurdere, om den ønskede egenskab er blevet ændret. Det kan for eksempel være, at den har mistet evnen til at smide sine frø, så de nu sidder fast på aksen, når de modnes frem for at blive spredt med vinden.
Det kan godt tage en transformation af hundrede- til tusindvis af celler for at få bare nogle redigerede planter. Nogle planter er mere resistente over for ændringer, mens andre ’tager bedre imod.’
Metoden kan virke enkel i princippet.
Men arbejdet med CRISPR kræver avanceret laboratorieudstyr og specialiserede faciliteter. Det indebærer blandt andet sterile arbejdsbænke, vækstkamre med kontrolleret temperatur og lysforhold, molekylærbiologisk udstyr til DNA-analyse samt trykkamre eller bakteriekulturer til transformation.
Samtidig er CRISPR en relativt billig og effektiv teknologi sammenlignet med tidligere metoder til genmodificering. Hvor ældre teknikker ofte var tidskrævende, upræcise og kostbare, gør CRISPR det muligt hurtigt og målrettet at ændre specifikke gener uden at indsætte store mængder fremmed DNA.
Netop derfor betragtes CRISPR som en milepæl i moderne genmodificeringsvidenskab.


